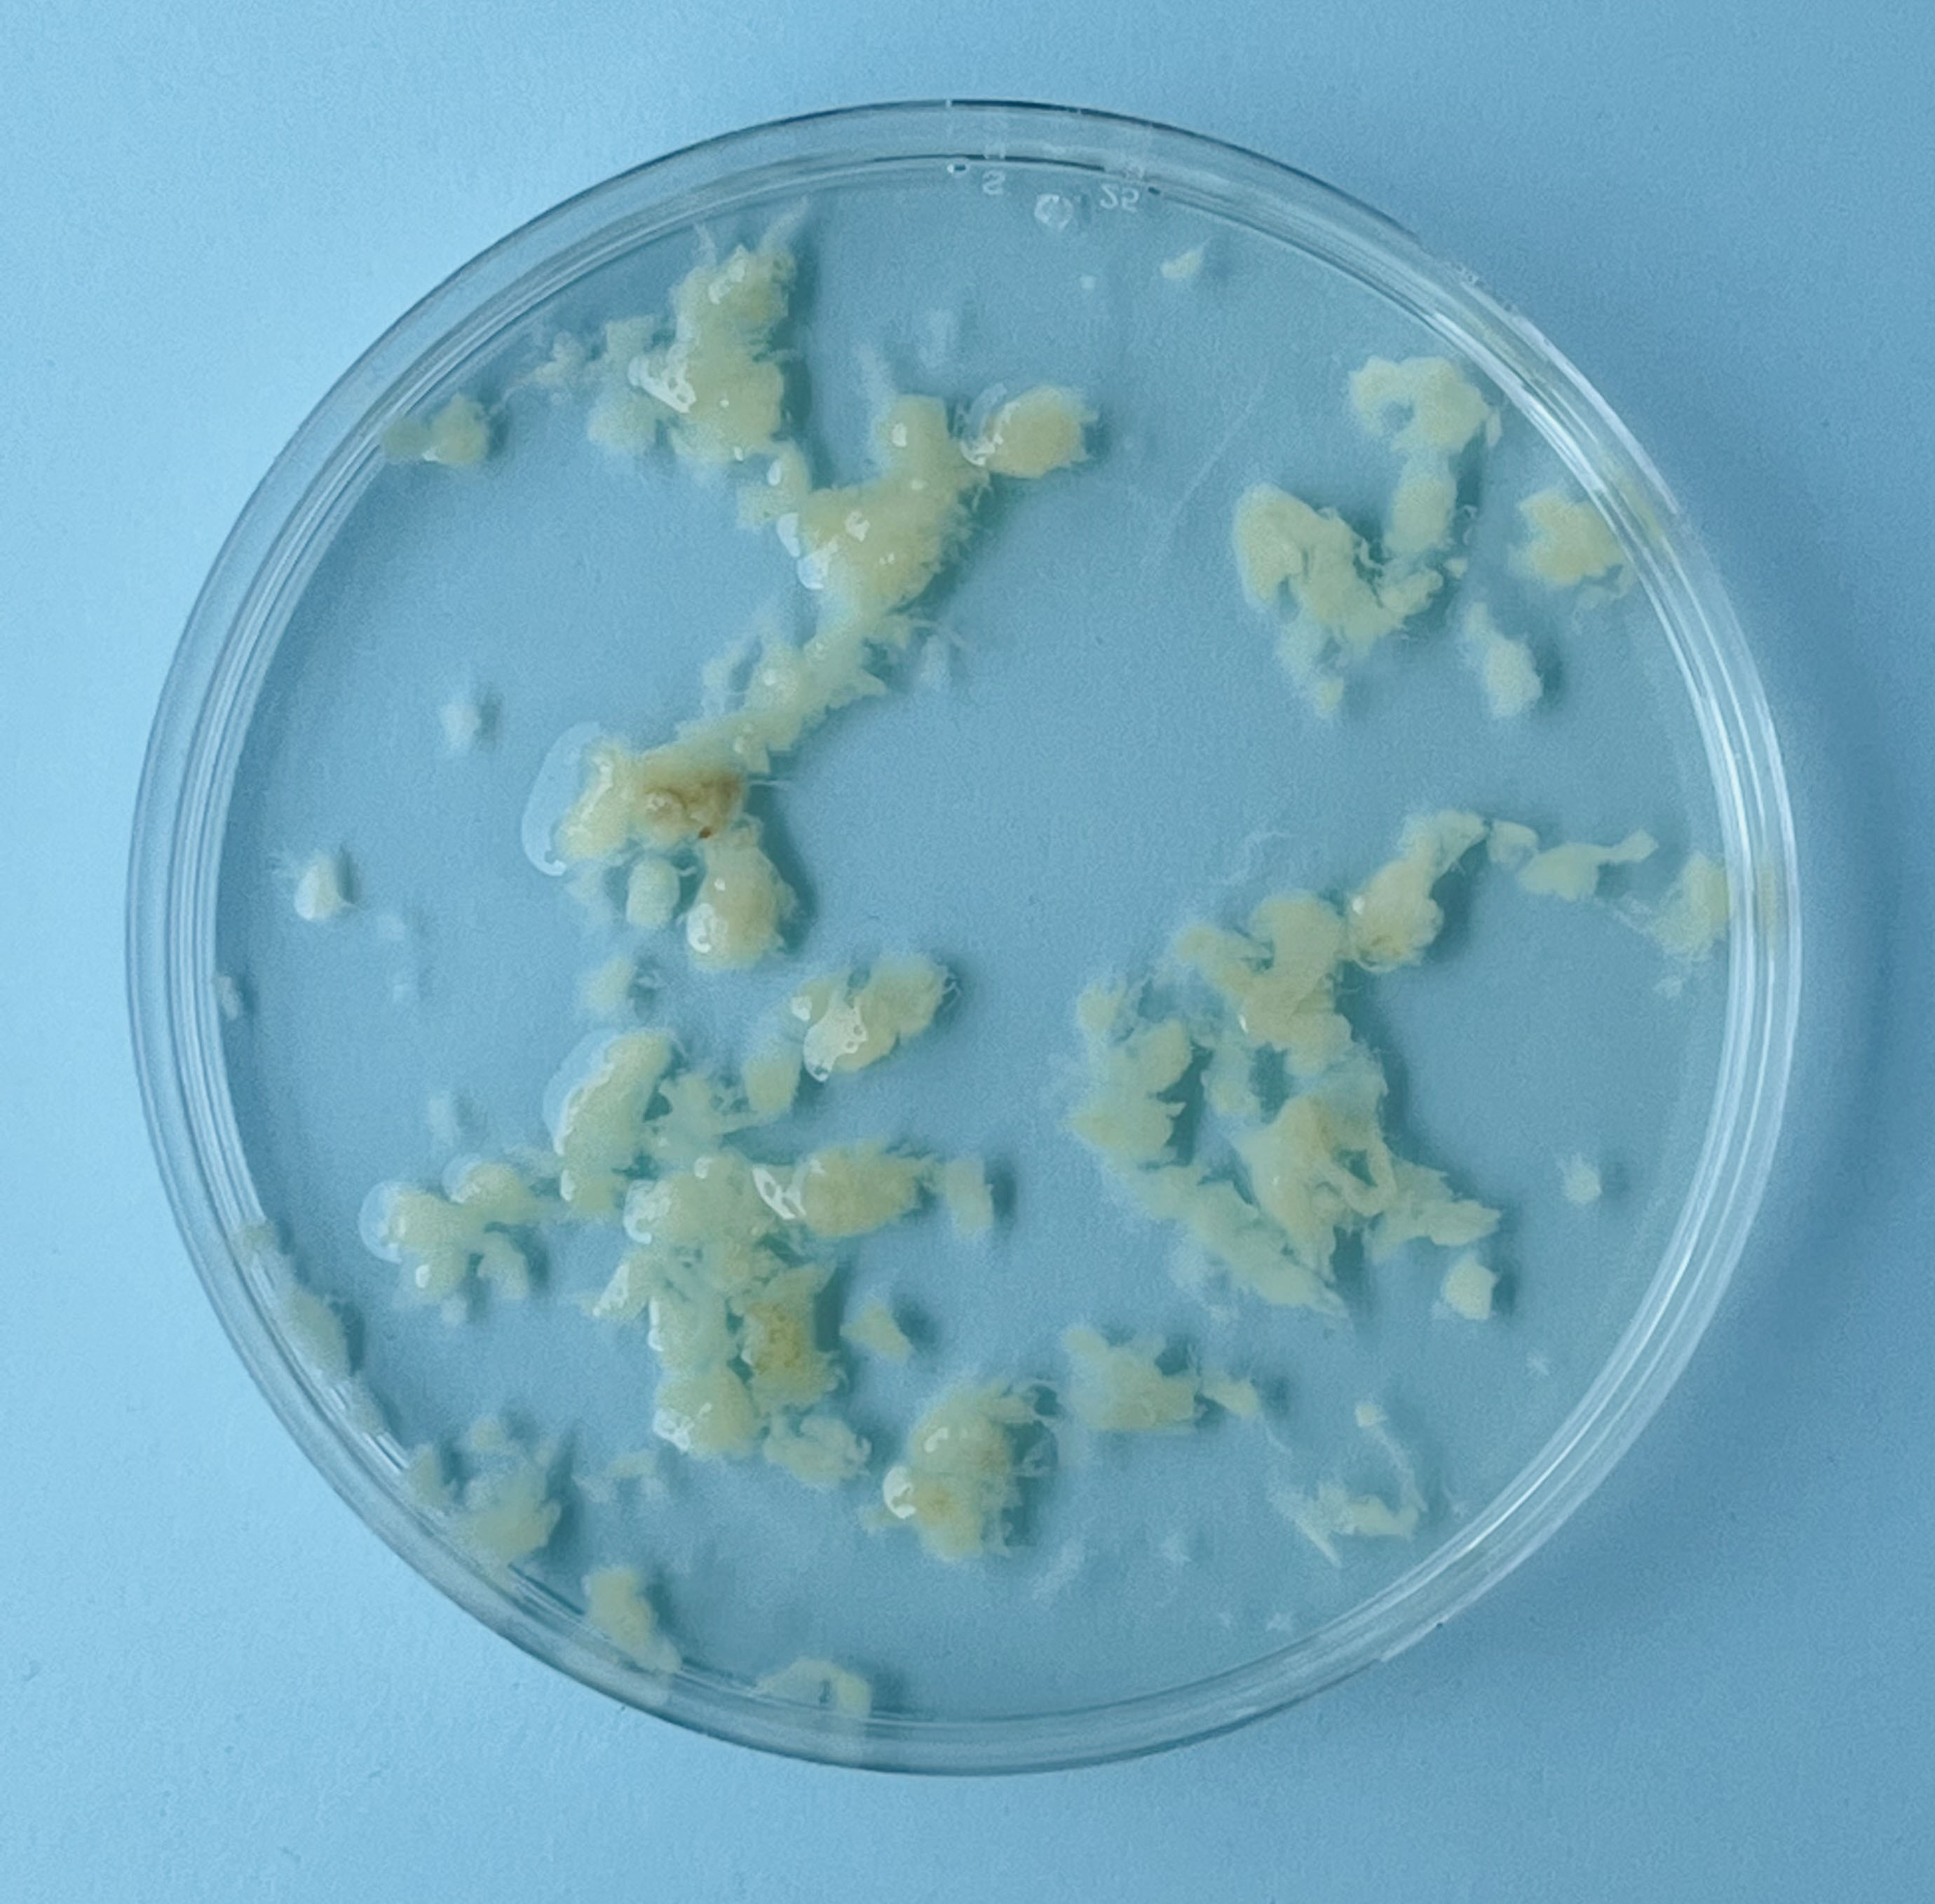

Embryo’s uit het lab
Onderzoek op menselijke embryo’s is in Nederland maar heel beperkt toegestaan. Daarom maken onderzoekers modellen van een embryo in het lab, ontwikkeld uit onder andere huidcellen van een volwassen mens. Zo hopen ze meer te leren over de allervroegste menselijke ontwikkeling. Hoe moeten we hiernaar kijken? Zijn het klompjes cellen of begin van een soort kunstmatige vorm van mini-mensjes?
De eindredacteuren zijn Marcia van Woensel, Erica Renckens en Mathilde Jansen.
De meeste artikelen zijn geschreven door Anne van Kessel en Lianne Tijhaar.
Stijn Schreven maakte de illustraties.
Colofon
Waarom krijgt iemand een spier- of bloedziekte? En kan je die vreselijke aandoeningen voorkomen? Om dit goed te kunnen onderzoeken, maken wetenschappers modellen van embryo's. Ze doen dat niet vanuit een zaadje en een eicel, zoals normaal een embryo ontstaat, maar vanuit stamcellen. Hoe kijk jij hiernaar? Is dit een klompje cellen of een minimens?
Mijn onderzoek heeft geen strakke verhaallijn, ik weet niet waar deze weg heengaat.
Die vraag is makkelijker gesteld, dan beantwoord. In deze serie lees je verschillende antwoorden op deze vraag.
In het embryo-debat worden nogal eens begrippen gebruikt die voor verwarring kunnen zorgen.
Wetenschappers hebben een model ontwikkeld dat sterk lijkt op een menselijk embryo.

Leven bouwen met moleculen
Kunnen we de natuur imiteren in het lab?
Zonder het vermogen van moleculen om zichzelf te organiseren zou jij niet bestaan. In de natuur zie je het overal: verschillende moleculen klitten samen tot onderdelen van cellen, die zich weer organiseren tot complete cellen. Cellen vormen weefsels, weefsels vormen organen, en organen vormen organismen. Hoever komen chemici met het imiteren van die werkwijze?